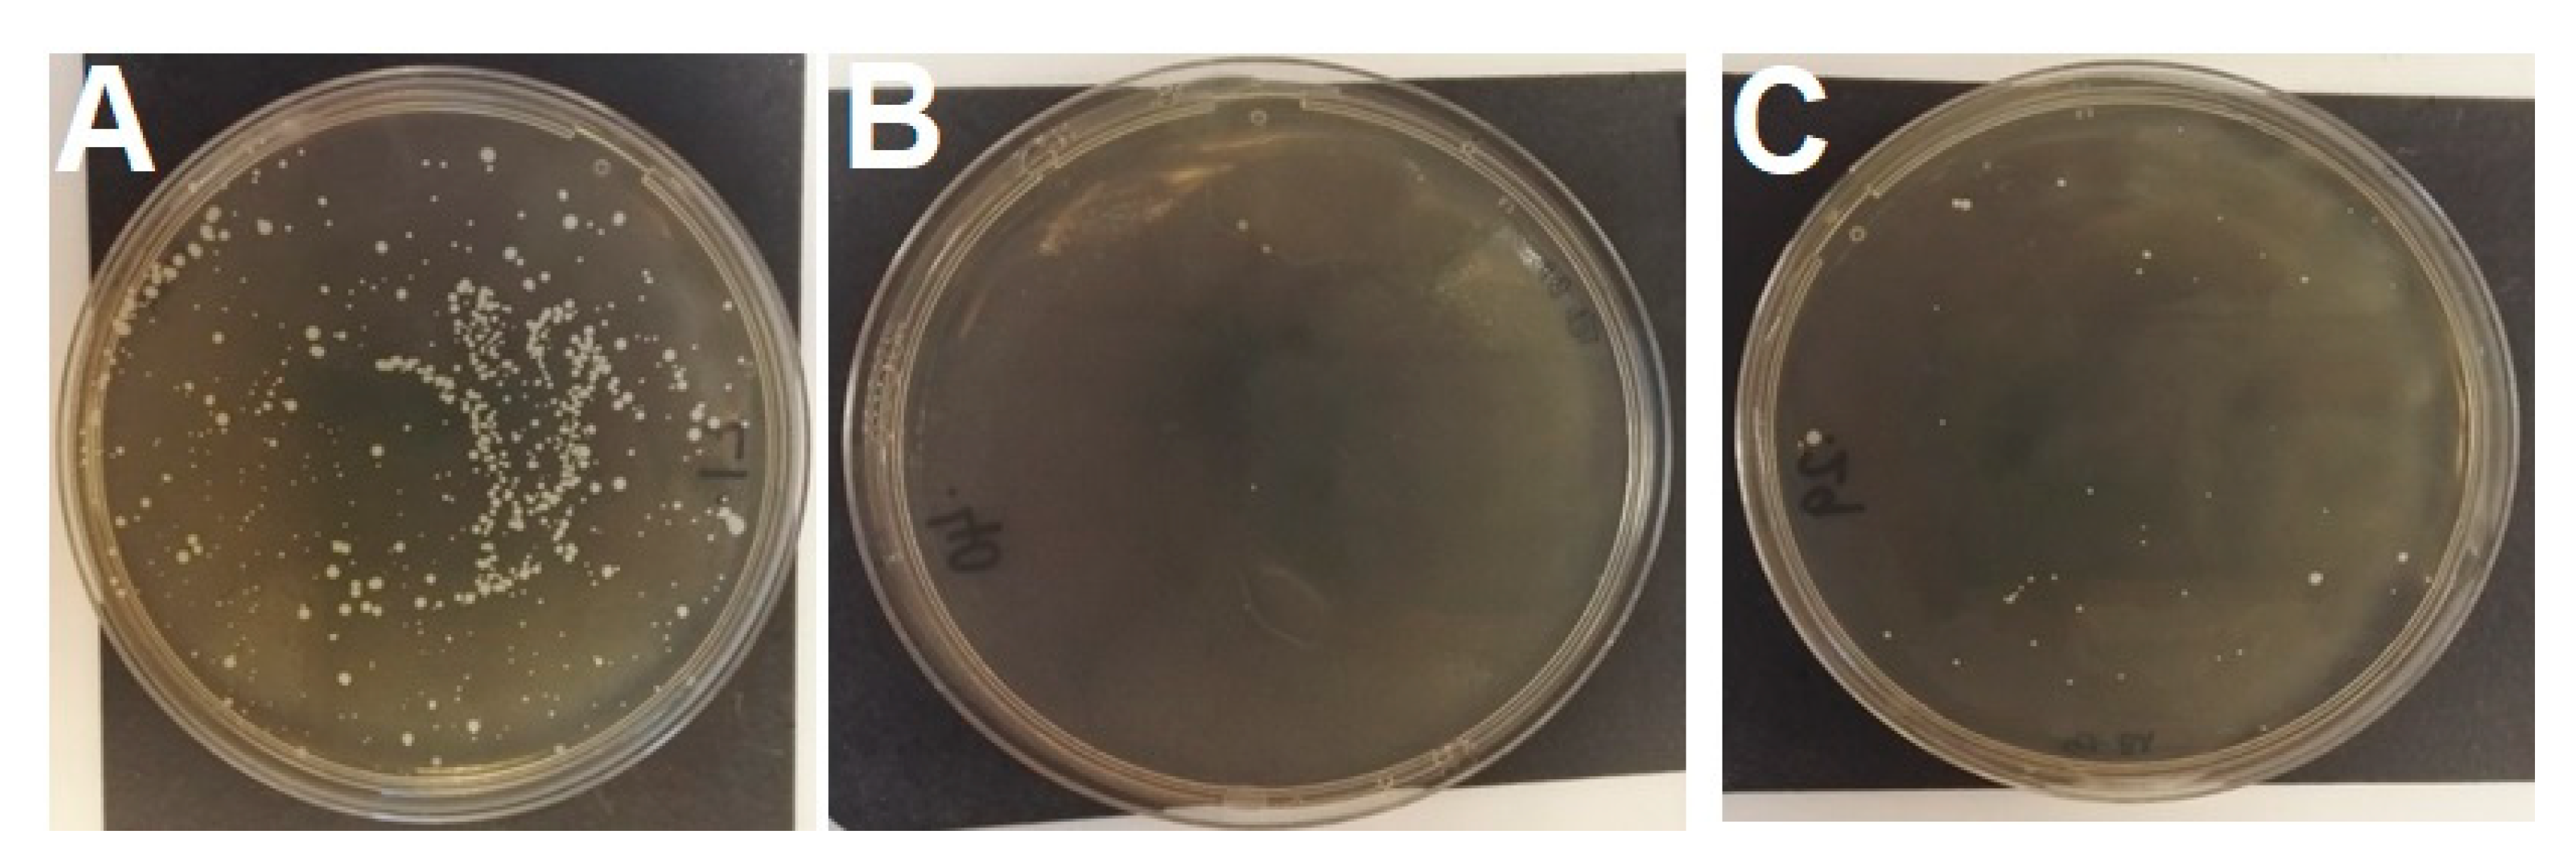
Microorganisms 08 02031 g001

Genes on the Move: In Vitro Transduction of Antimicrobial Resistance Genes between Human and Canine Staphylococcal Pathogens
Abstract
1. Introduction
2. Materials and Methods
2.1. Bacterial Isolates
2.2. Induction of Bacteriophage
2.3. Bacteriophage Count
2.4. Bacteriophage Transduction
2.5. Confirmation of Suspected Transductants
2.6. Statistical Analyses
3. Results
3.1. Bacteriophage Count
3.2. Transduction of Tetracycline Resistance
3.3. Transduction of FA Resistance
4. Discussion
Author Contributions
Funding
Acknowledgments
Conflicts of Interest
References
- Schwarz, S.; Loeffler, A.; Kadlec, K. Bacterial resistance to antimicrobial agents and its impact on veterinary and human medicine. Adv. Vet. Dermatol. 2017. [Google Scholar] [CrossRef]
- Zhen, X.; Lundborg, C.S.; Sun, X.; Hu, X.; Dong, X. Economic burden of antibiotic resistance in ESKAPE organisms: A systematic review. Antimicrob. Resist. Infect. Control 2019, 8, 137. [Google Scholar] [CrossRef] [PubMed]
- Van Hal, S.J.; Jensen, S.O.; Vaska, V.L.; Espedido, B.A.; Paterson, D.L.; Gosbell, I.B. Predictors of mortality in Staphylococcus aureus bacteremia. Clin. Microbiol. Rev. 2012, 25, 362–386. [Google Scholar] [CrossRef] [PubMed]
- Loeffler, A.; Lloyd, D.H. Companion animals: A reservoir for methicillin-resistant Staphylococcus aureus in the community. Epidemiol. Infect. 2010, 138, 595–605. [Google Scholar] [CrossRef]
- Loeffler, A.; Linek, M.; Moodley, A.; Guardabassi, L.; Sung, J.M.L.; Winkler, M.; Weiss, R.; Lloyd, D.H. First report of multiresistant, mecA-positive Staphylococcus intermedius in Europe: 12 cases from a veterinary dermatology referral clinic in Germany. Vet. Dermatol. 2007, 18, 412–421. [Google Scholar] [CrossRef]
- van Hoovels, L.; Vankeerberghen, A.; Boel, A.; van Vaerenbergh, K.; de Beenhouwer, H. First case of Staphylococcus pseudintermedius infection in a human. J. Clin. Microbiol. 2006, 44, 4609–4612. [Google Scholar] [CrossRef]
- Loeffler, A.; Boag, A.K.; Sung, J.; Lindsay, J.A.; Guardabassi, L.; Dalsgaard, A.; Smith, H.; Stevens, K.B.; Lloyd, D.H. Prevalence of methicillin-resistant Staphylococcus aureus among staff and pets in a small animal referral hospital in the UK. J. Antimicrob. Chemother. 2005, 56, 692–697. [Google Scholar] [CrossRef]
- Börjesson, S.; Gómez-Sanz, E.; Ekström, K.; Torres, C.; Grönlund, U. Staphylococcus pseudintermedius can be misdiagnosed as Staphylococcus aureus in humans with dog bite wounds. Eur. J. Clin. Microbiol. Infect. Dis. 2015, 34, 839–844. [Google Scholar] [CrossRef]
- Walther, B.; Hermes, J.; Cuny, C.; Wieler, L.H.; Vincze, S.; Elnaga, Y.A.; Stamm, I.; Kopp, P.A.; Kohn, B.; Witte, W.; et al. Sharing more than friendship—Nasal colonization with coagulase-positive staphylococci (CPS) and co-habitation aspects of dogs and their owners. PLoS ONE 2012, 7, e35197. [Google Scholar] [CrossRef]
- Partridge, S.R.; Kwong, S.M.; Firth, N.; Jensen, S.O. Mobile genetic elements associated with antimicrobial resistance. Clin. Microbiol. Rev. 2018, 31, e00088-17. [Google Scholar] [CrossRef]
- von Wintersdorff, C.J.H.; Penders, J.; van Niekerk, J.M.; Mills, N.D.; Majumder, S.; van Alphen, L.B.; Savelkoul, P.H.M.; Wolffs, P.F.G. Dissemination of antimicrobial resistance in microbial ecosystems through horizontal gene transfer. Front. Microbiol. 2016, 7, 173. [Google Scholar] [CrossRef] [PubMed]
- Lindsay, J.A. Staphylococcus aureus genomics and the impact of horizontal gene transfer. Int. J. Med. Microbiol. 2014, 304, 103–109. [Google Scholar] [CrossRef] [PubMed]
- Bannoehr, J.; Guardabassi, L. Staphylococcus pseudintermedius in the dog: Taxonomy, diagnostics, ecology, epidemiology and pathogenicity. Vet. Dermatol. 2012, 23, 253–266. [Google Scholar] [CrossRef] [PubMed]
- Brooks, M.R.; Padilla-Vélez, L.; Khan, T.A.; Qureshi, A.A.; Pieper, J.B.; Maddox, C.W.; Alam, M.D. Prophage-mediated disruption of genetic competence in Staphylococcus pseudintermedius. mSystems 2020, 5, e00684-19. [Google Scholar] [CrossRef] [PubMed]
- McCarthy, A.J.; Harrison, E.M.; Stanczak-Mrozek, K.; Leggett, B.; Waller, A.; Holmes, M.A.; Lloyd, D.H.; Lindsay, J.A.; Loeffler, A. Genomic insights into the rapid emergence and evolution of MDR in Staphylococcus pseudintermedius. J. Antimicrob. Chemother. 2015, 70, 997–1007. [Google Scholar] [CrossRef]
- McCarthy, A.J.; Witney, A.A.; Lindsay, J.A. Staphylococcus aureus temperate bacteriophage: Carriage and horizontal gene transfer is lineage associated. Front. Cell. Infect. Microbiol. 2012, 2, 1–10. [Google Scholar] [CrossRef]
- Naidoo, J.; Lloyd, D.H. Transmission of genes between staphylococci on skin. In Antimicrobials and Agriculture; Woodbine, M., Ed.; Butterworths: London, UK, 1984; pp. 282–295. [Google Scholar]
- Sung, J.M.L.; Lindsay, J.A. Staphylococcus aureus strains that are hypersusceptible to resistance gene transfer from enterococci. Antimicrob. Agents Chemother. 2007, 51, 2189–2191. [Google Scholar] [CrossRef]
- Couto, I.; de Lencastre, H.; Severina, E.; Kloos, W.; Webster, J.A.; Hubner, R.J.; Sanches, I.S.; Tomasz, A. Ubiquitous presence of a mecA homologue in natural isolates of Staphylococcus Sciuri. Microb. Drug Resist. 1996, 2, 377–391. [Google Scholar] [CrossRef]
- Rolo, J.; Worning, P.; Nielsen, J.B.; Sobral, R.; Bowden, R.; Bouchami, O.; Damborg, P.; Guardabassi, L.; Perreten, V.; Tomasz, A.; et al. Evidence for the evolutionary steps leading to mecA-mediated β-lactam resistance in staphylococci. PLoS Genet. 2017, 13, e1006674. [Google Scholar] [CrossRef]
- McCarthy, A.J.; Loeffler, A.; Witney, A.A.; Gould, K.A.; Lloyd, D.H.; Lindsay, J.A. Extensive horizontal gene transfer during Staphylococcus aureus co-colonization in vivo. Genome Biol. Evol. 2014, 6, 2697–2708. [Google Scholar] [CrossRef]
- Critically Important Antimicrobials for Human Medicine, 6th ed.; Licence: CC BY-NC-SA 3.0 IGO; World Health Organization: Geneva, Switzerland, 2019.
- Hur, B.A.; Hardefeldt, L.Y.; Verspoor, K.M.; Baldwin, T.; Gilkerson, J.R. Describing the antimicrobial usage patterns of companion animal veterinary practices; free text analysis of more than 4.4 million consultation records. PLoS ONE 2020, 15, e0230049. [Google Scholar] [CrossRef]
- Mateus, A.; Brodbelt, D.C.; Barber, N.; Stärk, K.D. Antimicrobial usage in dogs and cats in first opinion veterinary practices in the UK. J. Small Anim. Pract. 2011, 52, 515–521. [Google Scholar] [CrossRef] [PubMed]
- Farrell, D.J.; Castanheira, M.; Chopra, I. Characterization of global patterns and the genetics of fusidic acid resistance. Clin. Infect. Dis. 2011, 52, S487–S492. [Google Scholar] [CrossRef] [PubMed]
- O’Neill, A.J.; McLaws, F.; Kahlmeter, G.; Henriksen, A.S.; Chopra, I. Genetic basis of resistance to fusidic acid in staphylococci. Antimicrob. Agents Chemother. 2007, 51, 1737–1740. [Google Scholar] [CrossRef]
- De Briyne, N.; Atkinson, J.; Pokludová, L.; Borriello, S.P. Antibiotics used most commonly to treat animals in Europe. Vet. Rec. 2014, 175, 325. [Google Scholar] [CrossRef] [PubMed]
- McCarthy, A.J.; Lindsay, J.A. The distribution of plasmids that carry virulence and resistance genes in Staphylococcus aureus is lineage associated. BMC Microbiol. 2012, 12, 104. [Google Scholar]
- Toleman, M.S.; Reuter, S.; Jamrozy, D.; Wilson, H.J.; Blane, B.; Harrison, E.M.; Coll, F.; Hope, R.J.; Kearns, A.; Parkhill, J.; et al. Prospective genomic surveillance of methicillin-resistant Staphylococcus aureus (MRSA) associated with bloodstream infection, England, 1 October 2012 to 30 September 2013. Eurosurveillance 2019, 24, 1800215. [Google Scholar] [CrossRef]
- Frosini, S.M.; Bond, R.; Rantala, M.; Grönthal, T.; Rankin, S.C.; O’Shea, K.; Timofte, D.; Schmidt, V.; Lindsay, J.; Loeffler, A. Genetic resistance determinants to fusidic acid and chlorhexidine in variably susceptible staphylococci from dogs. BMC Microbiol. 2019, 19, 81. [Google Scholar] [CrossRef]
- Strommenger, B.; Kettlitz, C.; Werner, G.; Witte, W. Multiplex PCR assay for simultaneous detection of nine clinically relevant antibiotic resistance genes in Staphylococcus aureus. J. Clin. Microbiol. 2003, 41, 4089–4094. [Google Scholar] [CrossRef]
- Behzadi, E.; Behzadi, P. An in vitro study on the apoptosis inducing effects of ultraviolet B light in Staphylococcus aureus. Maedica 2012, 7, 54–57. [Google Scholar]
- Stanczak-Mrozek, K.I.; Laing, K.G.; Lindsay, J.A. Resistance gene transfer: Induction of transducing phage by sub-inhibitory concentrations of antimicrobials is not correlated to induction of lytic phage. J. Antimicrob. Chemother. 2017, 72, 1624–1631. [Google Scholar] [CrossRef] [PubMed]
- Damborg, P.; Broens, E.M.; Chomel, B.B.; Guenther, S.; Pasmans, F.; Wagenaar, J.A.; Weese, J.S.; Wieler, L.H.; Windahl, U.; Vanrompay, D.; et al. Bacterial zoonoses transmitted by household pets: State-of-the-art and future perspectives for targeted research and policy actions. J. Comp. Pathol. 2016, 155, S27–S40. [Google Scholar] [CrossRef] [PubMed]
- Uchiyama, J.; Takemura-Uchiyama, I.; Sakaguchi, Y.; Gamoh, K.; Kato, S.; Daibata, M.; Ujihara, T.; Misawa, N.; Matsuzaki, S. Intragenus generalized transduction in Staphylococcus spp. by a novel giant phage. ISME J. 2014, 8, 1949–1952. [Google Scholar] [CrossRef] [PubMed]
- Morikawa, K.; Takemura, A.J.; Inose, Y.; Tsai, M.; Nguyen Thi, L.T.; Ohta, T.; Msadek, T. Expression of a cryptic secondary Sigma Factor gene unveils natural competence for DNA transformation in Staphylococcus aureus. PLoS Pathog. 2012, 8, e1003003. [Google Scholar] [CrossRef] [PubMed]
- Friedmann, E.; Son, H. The human-companion animal bond: How humans benefit. Vet. Clin. N. Am. Small Anim. Pract. 2009, 39, 293–326. [Google Scholar] [CrossRef] [PubMed]
| Donor | ||||||||||
|---|---|---|---|---|---|---|---|---|---|---|
| tet(K) | tet(M) | fusB | fusC | |||||||
| MRSA (Human Hospital Environment) | MRSP (Canine Infection) | MRSP (Canine Infection) | MRSP (Canine Infection) | |||||||
| COL | 1726 | P0983 | P1067 | V1061 | V1100 | P1248 | ||||
| CC8 (ST250) | ST261 | ST621 | ST1090 | ST668 | ST668 | ST305 | ||||
| Recipient | MSSP (Canine Infection) | 221833 | ST263 | 1/10 | 3/10 | Not Done | ||||
| 287735 | ST82 | 0/3 | 1/10 | |||||||
| 289869 | ST54 | 0/3 | 0/3 | |||||||
| 289595 | ST1903 | 1/10 | 4/10 | |||||||
| 289589 | ST1907 | 0/3 | 0/3 | |||||||
| 289418 | ST1905 | 1/10 | 0/3 | |||||||
| 289385 | ST1906 | 0/3 | 0/3 | |||||||
| V1273 | ST1085 | Not Done | 0/3 | 0/3 | 0/3 | 0/3 | 0/3 | |||
| V0451 | ST1091 | 0/3 | 0/3 | 0/3 | 1/3 | 0/3 | ||||
| V0806 | ST54 | 0/3 | 0/3 | 0/3 | 0/3 | 0/3 | ||||
| P1361 | ST1086 | 0/3 | 0/3 | 0/3 | 0/3 | 0/3 | ||||
| P1351 | ST21 | 0/3 | 0/3 | 0/3 | 0/3 | 0/3 | ||||
| P1356 | ST1092 | 0/3 | 0/3 | 0/3 | 0/3 | 0/3 | ||||
| 251648 | ST71 | 0/3 | 0/3 | 1/3 | 0/3 | 0/3 | ||||
| 70361 | ST1087 | 0/3 | 0/3 | 0/3 | 0/3 | 0/3 | ||||
| MSSA (Canine Infection) | B019 | CC15 (ST15) | Not done | 0/3 | 1/3 | 0/3 | 1/3 | 0/3 | 1/3 | |
| B021 | CC15 (ST15) | 0/3 | 0/3 | 0/3 | 0/3 | 0/3 | 0/3 | |||
| B027 | CC15 (ST15) | 0/3 | 0/3 | 0/3 | 0/3 | 0/3 | 0/3 | |||
| Restriction-deficient MSSA (Laboratory Strain) | RN4220 | CC8 (ST8) | 4/10 | 0/3 | 0/3 | 0/3 | 0/3 | 0/3 | 0/3 | |
| Restriction-deficient MRSA (Laboratory Strain) | NE667 (hsdR mutant of JE2) | CC8 (ST8) | Not done | 0/3 | 0/3 | 0/3 | 0/3 | 0/3 | 0/3 | |
| MRSA (Human Infection) | JE2 | CC8 (ST8) | 0/3 | 0/3 | 1/3 | 0/3 | 1/3 | 1/3 | ||
| J220 | CC8 (ST239) | Not done | 0/3 | 0/3 | 1/3 | 2/3 | 0/3 | |||
| J225 | CC8 (ST239) | 1/3 | 0/3 | 1/3 | 0/3 | 0/3 | ||||
| FPR3757 | CC8 (ST8) | 2/3 | 0/3 | 0/3 | 0/3 | 0/3 | ||||
| MRSA (Human Carriage) | 19B | CC22 | 0/3 | 0/3 | 0/3 | 0/3 | 0/3 | 0/3 | ||
| TW20 | CC8 (ST239) | Not done | 0/3 | 0/3 | 2/3 | 1/3 | 0/3 | |||
| MRSA (Human Hospital Environment) | COL | CC8 (ST250) | 0/3 | 0/3 | 0/3 | 0/3 | 0/3 | |||
| Total number transduction assays per antimicrobial | 115 | 300 | ||||||||
| Total plates with increased growth /total number of transduction assays | 7/52 | 8/63 | 4/60 | 1/60 | 6/60 | 5/60 | 2/60 | |||
| Donor | Recipient | Number of Successful Transduction Assay Replicates | Median (Range) Transductant Cells/mL | |||
|---|---|---|---|---|---|---|
| Bacterial Type | Isolate | Tetracycline Resistance Gene | Bacterial Type | Isolate | ||
| MRSP | 1726 | tet(M) | MSSP | 221833 | 3/10 | 1105 (250–1510) |
| 287735 | 1/10 | 1535 | ||||
| 289595 | 4/10 | 92.5 (25–160) | ||||
| MRSA | COL | tet(K) | MSSP | 221833 | 1/10 | 1475 |
| 289595 | 1/10 | 65 | ||||
| 259418 | 1/10 | 40 | ||||
| RM-def MSSA | RN4220 | 4/10 | 62.5 (25–995) | |||
| Staphylococci | Original Recipient (Recipient MIC [mg/L]) | Mutant MIC (mg/L) | Amino Acid Substitution | Nucleotide Substitution |
|---|---|---|---|---|
| MSSP | 251648 (0.06) | 32 | H457Y | CAC → TAC |
| MSSA | B019 (0.06) | 32 | H457Y | CAC → TAC |
| 32 | F88L | TTC → CTC | ||
| MRSA | TW20 (0.06) | 32 | F88L | TTC → TTA |
| J220 (0.06) | >64 | H457N | CAC → AAC | |
| 32 | H457Y | CAC → TAC | ||
| J225 (0.06) | 32 | H457Y | CAC → TAC | |
| 64 | H457N | CAC → AAC | ||
| 64 | H457N | CAC → AAC | ||
| FPR3757 (0.06) | 64 | H457L | CAC → CTC | |
| JE2 (0.06) | 32 | H457Y | CAC → TAC |
Publisher’s Note: MDPI stays neutral with regard to jurisdictional claims in published maps and institutional affiliations. |
© 2020 by the authors. Licensee MDPI, Basel, Switzerland. This article is an open access article distributed under the terms and conditions of the Creative Commons Attribution (CC BY) license (http://creativecommons.org/licenses/by/4.0/).
Share and Cite
Frosini, S.M.; Bond, R.; McCarthy, A.J.; Feudi, C.; Schwarz, S.; Lindsay, J.A.; Loeffler, A. Genes on the Move: In Vitro Transduction of Antimicrobial Resistance Genes between Human and Canine Staphylococcal Pathogens. Microorganisms 2020, 8, 2031. https://doi.org/10.3390/microorganisms8122031
Frosini SM, Bond R, McCarthy AJ, Feudi C, Schwarz S, Lindsay JA, Loeffler A. Genes on the Move: In Vitro Transduction of Antimicrobial Resistance Genes between Human and Canine Staphylococcal Pathogens. Microorganisms. 2020; 8(12):2031. https://doi.org/10.3390/microorganisms8122031
Chicago/Turabian StyleFrosini, Sian Marie, Ross Bond, Alex J. McCarthy, Claudia Feudi, Stefan Schwarz, Jodi A. Lindsay, and Anette Loeffler. 2020. "Genes on the Move: In Vitro Transduction of Antimicrobial Resistance Genes between Human and Canine Staphylococcal Pathogens" Microorganisms 8, no. 12: 2031. https://doi.org/10.3390/microorganisms8122031
APA StyleFrosini, S. M., Bond, R., McCarthy, A. J., Feudi, C., Schwarz, S., Lindsay, J. A., & Loeffler, A. (2020). Genes on the Move: In Vitro Transduction of Antimicrobial Resistance Genes between Human and Canine Staphylococcal Pathogens. Microorganisms, 8(12), 2031. https://doi.org/10.3390/microorganisms8122031

